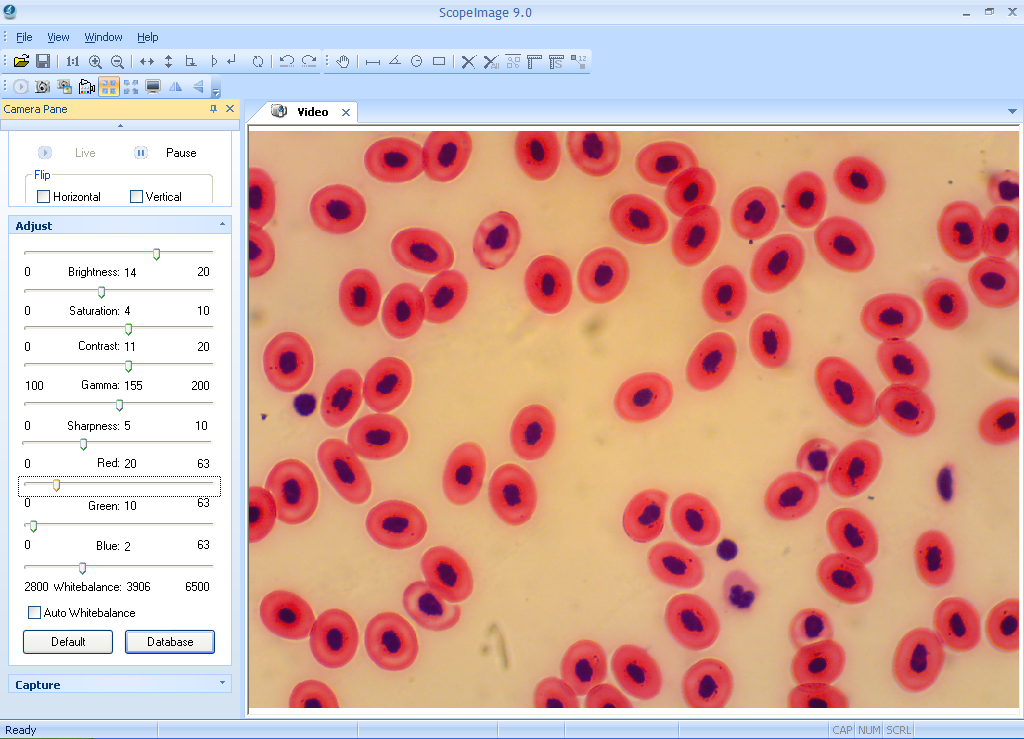

NOVEL 江南永新 ScopeImage 9.0 图像处理软件
技术规格
高分辨率摄像头处理软件是配合数码显微镜而开发,它的应用领域遍布光学显微镜所涉及的显微科研、生产、教学等多个领域,其友好的操作界面,稳定的性能为各领域的用户提供便捷的显微图像处理测量工具。
是专门为科研分析而开发的一款集图像预览、采集、分析处理于一体的专业数码显微图像软件,包含图像预览、捕捉、编辑、录像、缩放、测量、翻转、处理等等,主要特性如下:
1、多种实时图像预览方式:包括适合大小预览,冻结预览,实际大小预览,全屏预览等等,满足您多方面的预览需求。
2、控制面板的设计使得视频参数的调整非常方便,包括亮度,对比度,饱和度,RGB值,白平衡等等,可以在预览时对视频图像进行实时的色彩校正。
3、专门设计的色彩方案数据库,可将当前调整的色彩方案存入数据库,方便以后调用。
4、多种几何图形测量工具,包括直线测量、角度测量、矩形测量、圆测量、移动、删除、测量设置、生成测量数据等,可将测量信息科融合到图片中,并保留下来。
5、多种图像处理功能:均值化、中值化、锐化、浮雕、负像、亮度、对比度、饱和度。
6、图像翻转功能,包括动态视频图像的水平镜像、垂直镜像,静态图像的旋转:旋转90度、旋转180度、旋转270度、任意角度。
7、图像的缩放:放大、缩小、1:1。
以下是图像示例

手机/微信:13242449659电话:0755-89355351 QQ:842471885 邮箱:842471885@qq.com